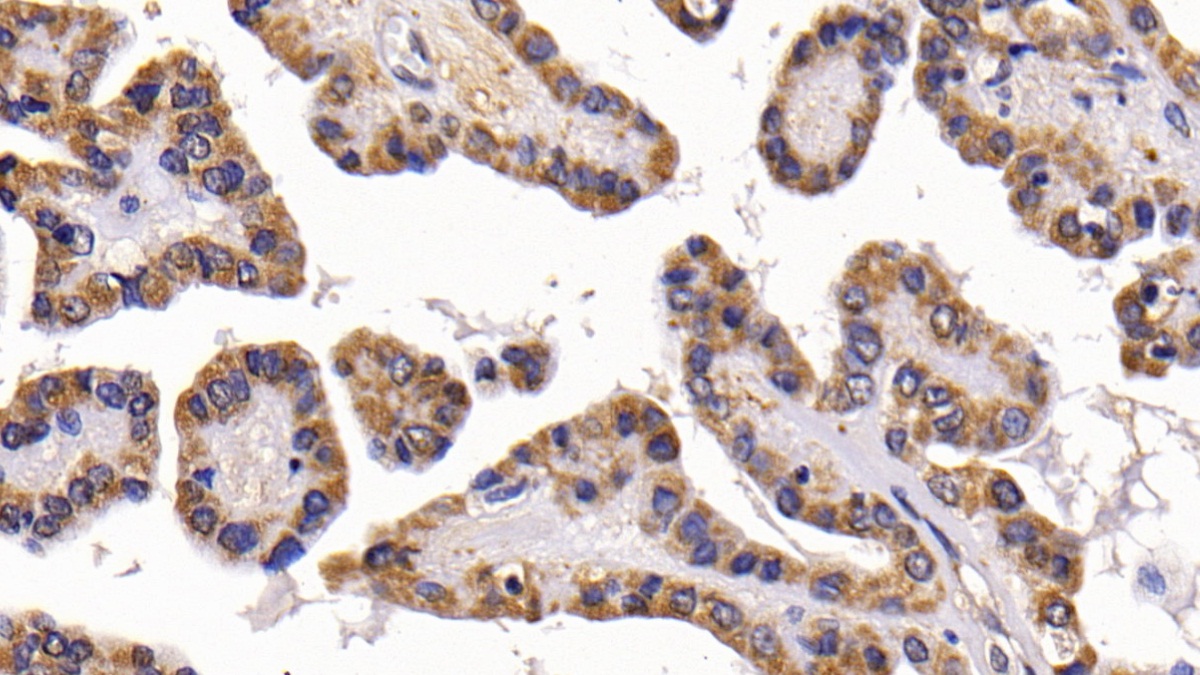

Polyclonal Antibody to Calcitonin (CT) 

CALCA; CALC1; KC; CCP; PDN-21; Katacalcin; Calcitonin carboxyl-terminal peptide
Overview
Properties
- Product No.PAA472Ge01
- Organism SpeciesPan-species (General) Same name, Different species.
- ApplicationsIHC
If the antibody is used in flow cytometry, please check FCM antibodies.
Research use only - Downloadn/a
- CategoryMetabolic pathwayEndocrinologyHormone metabolismBone metabolism
- SourcePolyclonal antibody preparation, Host Rabbit
- Ig Type IgG, Potency n/a
- PurificationAntigen-specific affinity chromatography followed by Protein A affinity chromatography
- LabelNone
- Immunogen n/a
- Buffer Formulation0.01M PBS, pH7.4, containing 0.05% Proclin-300, 50% glycerol.
- TraitsLiquid, Concentration 500µg/mL
Sign into your account
Share a new citation as an author
Upload your experimental result
Review

Contact us
Please fill in the blank.
Specifity
The antibody is a rabbit polyclonal antibody raised against CT. It has been selected for its ability to recognize CT in immunohistochemical staining and western blotting.
Usage
Immunohistochemistry: 5-20µg/mL
Immunocytochemistry: 5-20µg/mL
Optimal working dilutions must be determined by end user.
Storage
Store at 4°C for frequent use. Stored at -20°C in a manual defrost freezer for two year without detectable loss of activity. Avoid repeated freeze-thaw cycles.
Stability
The thermal stability is described by the loss rate. The loss rate was determined by accelerated thermal degradation test, that is, incubate the protein at 37°C for 48h, and no obvious degradation and precipitation were observed. The loss rate is less than 5% within the expiration date under appropriate storage condition.
Organism Species More: Homo sapiens (Human)Giveaways
Increment services
-
 Antibody Labeling Customized Service
Antibody Labeling Customized Service
-
 Protein A/G Purification Column
Protein A/G Purification Column
-
 Staining Solution for Cells and Tissue
Staining Solution for Cells and Tissue
-
 Positive Control for Antibody
Positive Control for Antibody
-
 Tissue/Sections Customized Service
Tissue/Sections Customized Service
-
 Phosphorylated Antibody Customized Service
Phosphorylated Antibody Customized Service
-
 Western Blot (WB) Experiment Service
Western Blot (WB) Experiment Service
-
 Immunohistochemistry (IHC) Experiment Service
Immunohistochemistry (IHC) Experiment Service
-
 Immunocytochemistry (ICC) Experiment Service
Immunocytochemistry (ICC) Experiment Service
-
 Flow Cytometry (FCM) Experiment Service
Flow Cytometry (FCM) Experiment Service
-
 Immunoprecipitation (IP) Experiment Service
Immunoprecipitation (IP) Experiment Service
-
 Immunofluorescence (IF) Experiment Service
Immunofluorescence (IF) Experiment Service
-
 Buffer
Buffer
-
 DAB Chromogen Kit
DAB Chromogen Kit
-
 SABC Kit
SABC Kit
-
 Long-arm Biotin Labeling Kit
Long-arm Biotin Labeling Kit
-
 Real Time PCR Experimental Service
Real Time PCR Experimental Service
Citations
- Effect of consumption of fatty acids, calcium, Vitamin D and boron with regular physical activity on bone mechanical properties and corresponding metabolic hormones in ratsNiscair: 13737
- The effect of supplementation of calcium, vitamin D, boron, and increased fluoride intake on bone mechanical properties and metabolic hormones in ratPubMed: 22782709
- Interleukin-2 and Lanreotide in the Treatment of Medullary Thyroid Cancer: In Vitro and In Vivo StudiesPubmed: 23884781
- Effect of whole body vibration on healthy rat plasma parametersEbscohost: Source
- Effect of consumption of fatty acids, nutrients and regular physical activity on bone mechanical properties in ratsPubmed:22439438
- Differences in biochemical and genetic biomarkers in patients with heart failure of various etiologies.pubmed:27448535
- Cell-matrix signals specify bone endothelial cells during developmental osteogenesis.pubmed:28218908
- Effects of fatty acids, nutrients and whole body vibration on bone histomorphometry, mechanical properties and metabolic parameters in male rat10.22192/ijarbs.2017.04.04.018
- p75NTR−/− mice exhibit an alveolar bone loss phenotype and inhibited PI3K/Akt/β‐catenin pathwayPubmed: 32215984
- Paracrine signalling by cardiac calcitonin controls atrial fibrogenesis and arrhythmiaPubmed: 33149301
- Copeptin in fluid disorders and stressPubmed:35143773